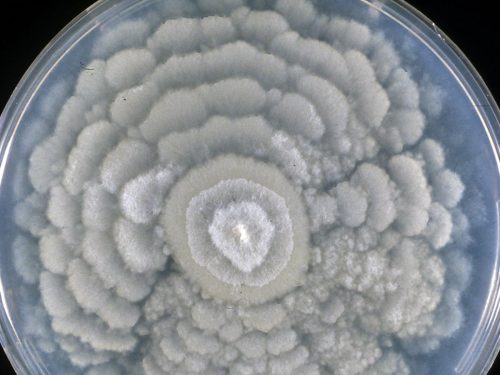

Fisica e biologia, due lati contrapposti dello scibile che interpreta e categorizza l’esistenza. Interconnessi negli effetti ma che possono costituire, in base alle circostanze, l’una o l’altra causa, mutualmente operative nell’imprimere specifiche derive al corso di determinati frangenti. Ed è forse per questo, più di ogni altra ragione, che l’idea umana di poter indurre precipitazioni atmosferiche in caso di prolungata siccità è da sempre stata simile ad un gesto magico almeno fino all’impiego di tecnologie moderne, così per l’approccio delle danze apotropaiche messe in opera in contesti tribali, come nel caso del proverbio americano delle Grandi Pianure secondo cui “La pioggia seguirà l’aratro” favorendo in questo modo il gesto di chi anticipa tramite il lavoro una progressione ciclica del ciclo stagionale. Caso vuole, tuttavia, che esista nella pratica un insieme di creature in grado di favorire in modo pratico questo fenomeno, dote che abbiamo lungamente attribuito a piccoli organismi che si moltiplicano come patogeni del mondo vegetale. Soltanto per venire sollevati, con un alito di vento, fino alle regioni nebulose dei cieli soprastanti. Dove favoriscono, tramite la secrezione di speciali proteine, la concrezione in schegge dell’umidità latente. Esatto: esistono batteri che possono costruire il ghiaccio. Che poi ricadono, liquefacendosi, per dissetare l’arido terreno sottostante. Soltanto grazie a un nuovo studio di scienziati appartenenti alla Boise University e il Virginia Tech, ora sappiamo in quale modo esatto certi esseri fungini possono riuscire a compiere la stessa impresa. Con finalità e un approccio differenti, calibrati sulla base di uno stile di sopravvivenza differente. Ma la stessa origine remota lungo l’albero pregresso dell’evoluzione, avendo incorporato, come ipotesi dal più elevato grado di pertinenza, tale propensione dalla flora batterica dei propri antichi predecessori. Dimostrando l’esistenza di un trasferimento genetico tra organismi tanto lontani, nei fatti, da non vantare casi precedenti a cui ispirarsi. Il che porta ad una serie di rivelazioni, sul funzionamento della vita fungina e il modo in cui può risultarci utile, che lo studio esamina in maniera approfondita. Soprattutto per quanto concerne il micelio saprofita del genere Mortierella e la muffa filamentosa Fusarium, il cui possesso della sovraesposta prerogativa permetterebbe, in base alla logica contestuale, di favorire una ripetizione ciclica da formazione del corpo fruttifero, sollevamento delle spore fino ad una quota sufficiente ad alterare la vigente meteorologia. Da cui la creazione di quel suolo umido, di per se stesso favorevole all’attecchimento della prossima generazione fungina…
Un tipo di fenomeno, dal punto di vista pratico, non troppo facile da visualizzare. E che una volta che ci si trova a sperimentarlo in via diretta, tramite l’osservazione materiale o digitale, risiede a pieno titolo tra quegli esperimenti che ricordano dei veri e propri giochi di prestigio. Ecco allora l’uomo con il camice che impugnando una pipetta, immette dentro una bottiglia poche gocce di una soluzione contenente vari tipi di patogeni, tra cui soprattutto lo Pseudomonas syringae. La cui capacità di secernere una classe particolare di proteine, dette INA o di “nucleazione attiva del ghiaccio” procede nell’indurre un’improvvisa quanto repentina solidificazione di quel fluido un tempo trasparente, presto trasformato in un singolo blocco solido di materiale bianco e lattiginoso. Ghiaccio, in altri termini, come quello che il batterio forma sulle piante bersaglio al fine d’indurre condizioni croniche di necrosi o gummosi, ideali vie di accesso per le parti maggiormente vulnerabili dell’organismo. Un fenomeno da lungo tempo utilizzato in campo tecnologico, come uno degli approcci possibili per la formazione della neve artificiale piuttosto che il cloud seeding, o seminazione delle nuvole, in qualità di alternativa percorribile ai più frequenti ioduro d’argento o ghiaccio secco. Ma che assai difficilmente avrebbe potuto trovare l’impiego per l’induzione graduale della glaciazione, nella conservazione di materia organica come campioni biologici, o perché no, sostanze commestibili impiegate nel sostentamento umano… Dopo tutto, qualsiasi batterio è per sua natura incline a riprodursi, con effetti difficilmente prevedibili e potenzialmente nocivi. Allorché figura come alternativa, nel modo paventato dalla stessa squadra di ricerca statunitense, la capacità dei funghi sopra menzionati di secernere lo stesso tipo di proteine, ma stavolta senza nessun tipo di cellule responsabili del loro trasporto. Favorendo almeno in linea di principio il loro impiego in vari campi inesplorati di quello che potremmo definire un nuovo tipo di congelamento naturale. Che non altera, in alcun modo apprezzabile, la composizione implicita della materia fatta oggetto di quel processo.
Trattasi, d’altronde, di nozione lungamente nota. Fin dagli anni ’90 il mondo accademico aveva desunto, per vie traverse, l’effettiva dote dei funghi ad accrescere la probabilità di precipitazioni. Così come il sapere aneddotico associava un particolare “odore” alla cessazione dei rovesci, derivante per l’appunto dai batteri parzialmente responsabili di tali eventi. Sebbene soltanto il nuovo approccio volto a combinare l’analisi genetica con il conteggio computazionale statistico, abbia permesso di comprendere le meccaniche precise di tali evenienze. Spalancando una finestra ulteriore non soltanto sul funzionamento pratico di un’intera classe di organismi, bensì anche l’opportunità di metterli in futuro al servizio del bene comune. Uno dei fattori più importanti, nel favorire l’ulteriore approfondimento di nuove materie di studio.
Ma questo non è tutto: così come gli antichi immaginavano di poter cambiare il cielo sgombro in nubi portatrici di vita, approccio non del tutto privo di fondamento (arare, dopotutto, favorisce la dispersione colloidale di molecole o microrganismi) non è oggi irragionevole pensare che l’analisi inversa per quanto concerne la diffusione di particolari specie micotiche possa contribuire all’elaborazione di modelli climatici migliori. Un’importante arma a disposizione dei moderni, nel massimizzare il successo agricolo e prevedere accuratamente il cambiamento dei processi meteorologici attuali. In quel ciclo progressivo in cui ciascun anello è progressione inevitabile nella curva catenaria, che induce l’elaborazione dal principio di partenza fino alle più estreme, ed umide, conseguenze. Non tutti i batteri, d’altronde, ci sono nemici. E certi funghi possono essere degli alleati. Se soltanto ci fermiamo, per qualche attimo, a ponderare l’effettivo funzionamento della natura.
Per approfondire: link allo studio A previously unrecognized class of fungal ice-nucleating proteins with bacterial ancestry – Science Advances, Eufemio, Rojas et al.